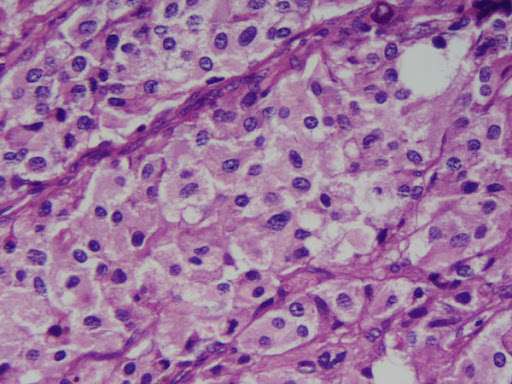
Feocromocitoma y Paraganglioma

Los feocromocitomas y los paragangliomas extra craneales no cervicales (conocidos colectivamente como PPGLs, por sus siglas en inglés) son tumores neuroendocrinos raros, cuya incidencia anual estimada oscila entre 2 y 6 casos por millón de habitantes. No obstante, esta cifra probablemente subestima su verdadera prevalencia, ya que numerosos casos no se diagnostican en vida. Estudios de autopsias han demostrado una prevalencia de aproximadamente 1 caso por cada 2000 cadáveres examinados, lo que sugiere una proporción significativa de tumores asintomáticos o no detectados clínicamente.
Estos tumores pueden localizarse en una o ambas glándulas suprarrenales, a lo largo de la cadena simpática paravertebral, y ocasionalmente en sitios atípicos como el mediastino, el corazón o la vejiga urinaria. El feocromocitoma se origina específicamente en la médula suprarrenal y se caracteriza por la producción de catecolaminas, principalmente adrenalina (epinefrina) y noradrenalina (norepinefrina). En contraste, los paragangliomas —a veces denominados «feocromocitomas extraadrenales»— derivan de los paraganglios simpáticos y presentan una mayor tendencia a la malignidad y a la metástasis.
Aproximadamente la mitad de los paragangliomas son funcionales, es decir, secretan noradrenalina. El resto son no funcionales o secretan otras sustancias como dopamina, normetanefrina o cromogranina A. Esta variabilidad en la secreción dificulta el diagnóstico y favorece la naturaleza insidiosa de estos tumores, los cuales pueden resultar mortales antes de ser identificados: al menos un tercio de los pacientes fallece sin haber recibido un diagnóstico oportuno.
A pesar de su peligrosidad, los PPGLs representan menos del 0,4 % de los casos de hipertensión arterial. Su incidencia aumenta entre niños hipertensos y en adultos con hipertensión moderada a severa, particularmente cuando se acompañan de síntomas sugestivos como cefaleas intensas, palpitaciones marcadas o episodios de diaforesis. Casi la mitad de los casos se descubre de manera incidental mediante estudios de imagen realizados por otras causas, representando alrededor del 4 % de los incidentalomas suprarrenales.
Por otro lado, los paragangliomas no secretorios suelen ubicarse en la región de la cabeza y el cuello, especialmente en el cuerpo carotídeo, la región yugulotimpánica o el cuerpo vagal. Sólo cerca del 4 % de estos tumores craneocervicales produce catecolaminas.
Desde el punto de vista genético, aproximadamente el 40 % de los pacientes con PPGLs presenta una mutación germinal en uno de al menos 16 genes conocidos que predisponen al desarrollo de estos tumores. Estas alteraciones suelen heredarse de forma autosómica dominante, aunque con penetrancia incompleta. En consecuencia, se recomienda realizar estudios genéticos a todos los pacientes diagnosticados con estas neoplasias, tanto por implicaciones pronósticas como por el posible riesgo hereditario en familiares.
La enfermedad de von Hippel–Lindau tipo 2 es un síndrome hereditario autosómico dominante caracterizado por una predisposición a desarrollar diversos tumores benignos y malignos en múltiples órganos, entre ellos el feocromocitoma. Esta neoplasia, derivada de células cromafines productoras de catecolaminas en la médula suprarrenal, se presenta en aproximadamente un 30 % de los individuos portadores de la mutación a lo largo de su vida. La aparición puede darse tan temprano como a los 5 años de edad, aunque también puede manifestarse en la adultez, lo que obliga a una vigilancia clínica desde la infancia en portadores conocidos.
En el contexto del síndrome von Hippel–Lindau, los feocromocitomas presentan un comportamiento clínico distintivo en comparación con sus contrapartes esporádicas. Son significativamente menos propensos a la malignidad, con una tasa de transformación maligna estimada en un 3,5 %, frente a cerca del 10 % en pacientes sin esta enfermedad genética. Además, tienen una menor tendencia a diseminarse en comparación con los paragangliomas extraadrenales, cuya tasa de metástasis alcanza entre un 20 y un 25 %. Esta menor agresividad no elimina su potencial letal, pero sí modifica el enfoque diagnóstico y terapéutico.
Una característica importante de los feocromocitomas asociados con von Hippel–Lindau es su presentación subclínica en una proporción considerable de pacientes. Alrededor del 25 % son asintomáticos y normotensos al momento del diagnóstico, lo que refleja la utilidad de los programas de tamizaje en familias afectadas, ya que permite la identificación precoz antes de la aparición de síntomas potencialmente peligrosos como crisis hipertensivas o arritmias.
Además del feocromocitoma, la enfermedad de von Hippel–Lindau tipo 2 se asocia con un amplio espectro de manifestaciones sistémicas, que incluyen hemangioblastomas de retina, cerebelo, tronco encefálico y médula espinal; hiperparatiroidismo; quistes pancreáticos; tumores del saco endolinfático; cistadenomas del epidídimo o anexos; tumores neuroendocrinos pancreáticos; así como quistes, adenomas y carcinoma de células renales. Esta amplia expresividad fenotípica obliga a un abordaje interdisciplinario del paciente y al seguimiento continuo de múltiples órganos.
En el marco de los síndromes genéticos que predisponen al feocromocitoma, también destacan otras entidades, como la neoplasia endocrina múltiple tipo 2 (MEN 2). La variante MEN 2A se caracteriza por la coexistencia de feocromocitoma, carcinoma medular de tiroides, hiperparatiroidismo y, en algunos casos, amiloidosis cutánea en forma de liquen. En estos pacientes, los feocromocitomas suelen ser silenciosos: solo alrededor del 50 % presentan síntomas al momento del diagnóstico y una proporción aún menor muestra hipertensión, posiblemente debido a la detección temprana mediante cribado anual en individuos portadores de mutaciones conocidas.
La neoplasia endocrina múltiple tipo 3 (también denominada MEN 2B) puede ser hereditaria, pero frecuentemente surge por una mutación de novo en el gen RET. Esta forma más agresiva se asocia con una alta incidencia de feocromocitomas (hasta un 50 %), carcinoma medular de tiroides de rápido crecimiento, neuromas mucosos y un fenotipo somático similar al del síndrome de Marfan, incluyendo habitus largo y delgado, hiperlaxitud articular y deformidades esqueléticas.
La neurofibromatosis tipo 1, también conocida como enfermedad de von Recklinghausen, incrementa el riesgo de desarrollar tanto feocromocitomas como paragangliomas. Esta enfermedad multisistémica se caracteriza por la presencia de neurofibromas cutáneos, gliomas ópticos y del tronco cerebral, astrocitomas, anomalías vasculares, hamartomas, tumores malignos de la vaina nerviosa, así como las clásicas manchas café con leche de bordes lisos. El espectro clínico de la neurofibromatosis tipo 1 es amplio y requiere un abordaje individualizado para la vigilancia de sus múltiples manifestaciones.
Manifestaciones clínicas
Las manifestaciones clínicas del feocromocitoma y del paraganglioma están profundamente determinadas por la forma en que el tumor es descubierto, debido a la heterogeneidad en su comportamiento secretor, localización anatómica, y respuesta fisiológica del organismo al exceso de catecolaminas. Esta variabilidad refleja tanto diferencias biológicas entre los tumores como el contexto clínico en el que se produce su detección.
Cuando el diagnóstico se realiza de manera anticipada, como ocurre en individuos portadores de mutaciones germinales predisponentes que son sometidos a programas de cribado genético, los tumores pueden encontrarse en fases tempranas, muchas veces antes de que se manifiesten clínicamente. En estos casos, los feocromocitomas pueden ser funcionales pero clínicamente silentes, o bien secretar cantidades modestas de catecolaminas, lo que resulta en un perfil sintomático escaso o ausente. De forma similar, el hallazgo incidental de un tumor suprarrenal durante estudios de imagen, como una tomografía computarizada realizada por otras razones médicas, puede revelar un feocromocitoma aún no sintomático, lo que refleja una fase de la enfermedad menos avanzada o una actividad bioquímica limitada del tumor.
En contraste, los feocromocitomas que se diagnostican debido a síntomas clínicos llamativos suelen ser funcionalmente activos, es decir, secretan cantidades excesivas y a menudo erráticas de catecolaminas como adrenalina, noradrenalina y, en menor medida, dopamina. Estos episodios de hipersecreción pueden desencadenar crisis adrenérgicas agudas, cuyas consecuencias clínicas dependen de la intensidad y duración de la descarga catecolaminérgica, así como de la susceptibilidad del sistema cardiovascular del paciente. Tales crisis pueden manifestarse como hipertensión paroxística o sostenida, arritmias cardíacas potencialmente letales, y síndromes coronarios agudos, e incluso conducir a la muerte súbita si no se diagnostican y manejan de forma oportuna.
Determinados estímulos mecánicos o farmacológicos pueden precipitar estas crisis en pacientes con feocromocitomas no diagnosticados. La manipulación del tumor durante procedimientos invasivos como biopsias con aguja fina, intervenciones quirúrgicas, anestesia general, o incluso eventos fisiológicos como el parto vaginal, pueden desencadenar una liberación masiva de catecolaminas con consecuencias cardiovasculares catastróficas. El ejercicio, el estrés emocional, el esfuerzo físico, o acciones tan cotidianas como orinar —en el caso de paragangliomas vesicales—, pueden precipitar síntomas severos. También ciertos fármacos, incluyendo descongestionantes, estimulantes del sistema nervioso central, antidepresivos y contrastes yodados, pueden inducir estas crisis mediante mecanismos farmacodinámicos que aumentan la actividad adrenérgica.
Desde el punto de vista clínico, las manifestaciones más frecuentes del feocromocitoma incluyen hipertensión arterial, que puede ser continua o episódica, cefalea, palpitaciones y diaforesis. Aproximadamente el sesenta por ciento de los pacientes experimenta crisis sintomáticas episódicas, muchas veces inespecíficas, descritas como “ataques” de ansiedad, sudoración profusa, temblor, náuseas o una sensación inminente de muerte. Las alteraciones vasculares transitorias pueden inducir fenómenos como cianosis, palidez facial, fenómeno de Raynaud o, al resolver la crisis, rubor facial y sudoraciones intensas.
El impacto sobre el sistema cardiovascular puede ser profundo: arritmias supraventriculares o ventriculares, insuficiencia cardíaca, miocardiopatía inducida por catecolaminas, e incluso estados de choque. Estos efectos están mediados por la toxicidad directa de las catecolaminas sobre el miocardio, así como por su efecto vasoconstrictor sistémico. En el sistema nervioso central, la vasoconstricción cerebral puede dar lugar a confusión, psicosis, convulsiones, ataques isquémicos transitorios o accidentes cerebrovasculares hemorrágicos. La afectación gastrointestinal también puede ocurrir, con dolor abdominal, vómitos, o incluso isquemia intestinal. En algunos casos, puede presentarse pérdida de peso, fiebre o manifestaciones neurosensoriales como parestesias.
Durante el embarazo, la presencia de un feocromocitoma puede mimetizar condiciones como la preeclampsia, con hipertensión y proteinuria, y conlleva un riesgo elevado de crisis hipertensivas durante el parto, seguidas de hipotensión posparto grave. En escenarios más avanzados, especialmente cuando existe diseminación metastásica, pueden presentarse síntomas derivados de la invasión ósea o la producción ectópica de hormonas peptídicas, como el ACTH (síndrome de Cushing), la hormona vasoactiva intestinal (síndrome de Verner-Morrison), o la proteína relacionada con la hormona paratiroidea (hipercalcemia).
Los feocromocitomas pueden precipitar una crisis multisistémica devastadora, caracterizada por colapso hemodinámico, insuficiencia respiratoria aguda, disfunción miocárdica, falla renal y hepática, y muerte. Este tipo de crisis puede presentarse de manera espontánea o ser desencadenada por intervenciones médicas o quirúrgicas. Por todo ello, la forma en que el tumor es descubierto —ya sea como hallazgo incidental, mediante cribado genético, o a raíz de una emergencia clínica— condiciona de forma decisiva el perfil sintomático del paciente y el pronóstico global de la enfermedad.
Exámenes diagnósticos
Laboratorio
En la actualidad, la medición de metanefrinas libres fraccionadas en plasma es el método más sensible para la detección de feocromocitomas y paragangliomas secretores. Estas metanefrinas, productos de la degradación de catecolaminas, reflejan la producción tumoral continua y espontánea, y no solo la liberación episódica, ofreciendo así una mayor sensibilidad diagnóstica. La sensibilidad de esta prueba alcanza aproximadamente el noventa y siete por ciento para tumores secretores, lo que implica que valores normales permiten descartar la enfermedad con un alto grado de certeza, salvo en contextos especiales, como en portadores de mutaciones germinales predisponentes, quienes pueden albergar tumores no secretores o aún en fases incipientes.
El contexto fisiológico en el que se realiza la prueba también influye en los resultados. Por ejemplo, las concentraciones de metanefrinas libres son consistentemente más bajas cuando el paciente está en posición supina, en comparación con el estado ambulatorio. Esta variación postural justifica la recomendación de realizar el estudio con el paciente en reposo supino durante un período previo de entre treinta y noventa minutos en un ambiente tranquilo, lo cual mejora la especificidad del análisis y reduce la incidencia de resultados falsos positivos.
Aun así, se estima que la tasa de falsos positivos de esta prueba puede alcanzar hasta el diecisiete por ciento, especialmente cuando las elevaciones de metanefrinas son leves. Existen indicadores bioquímicos que orientan hacia una interpretación errónea, como una relación de normetanefrina a noradrenalina menor de 0.52, o una relación de metanefrina a adrenalina menor de 4.2. En estos casos, es fundamental reevaluar al paciente bajo condiciones óptimas, eliminando factores confusos como el uso de fármacos interferentes, estados de convalecencia, o trastornos como la apnea del sueño. Se recomienda suspender medicamentos potencialmente responsables al menos dos semanas antes del nuevo análisis, y repetir la medición con el paciente en condiciones estandarizadas.
Para confirmar hallazgos marginales en plasma, se recurre habitualmente a la recolección de metanefrinas fraccionadas en orina de veinticuatro horas, junto con creatinina urinaria. Esta prueba complementaria permite verificar la existencia de una hipersecreción catecolaminérgica sostenida, típica de tumores funcionales. Los pacientes con feocromocitoma suelen presentar más de 2.2 microgramos de metanefrina total por miligramo de creatinina y más de 135 microgramos de catecolaminas totales por gramo de creatinina. Este análisis urinario tiene también una sensibilidad aproximada del noventa y siete por ciento para detectar tumores funcionantes.
En algunos escenarios específicos, como en tumores suprarrenales incidentales o pacientes normotensos con sospecha de paraganglioma, puede ser útil medir catecolaminas fraccionadas en plasma, particularmente si se sospecha secreción exclusiva de dopamina. Esta catecolamina puede actuar como marcador tumoral en ciertos subtipos funcionales atípicos. Asimismo, el nivel sérico de cromogranina A se encuentra elevado en aproximadamente el ochenta y cinco por ciento de los pacientes con feocromocitoma o paraganglioma, correlacionándose con el tamaño tumoral y siendo más alto en presencia de enfermedad metastásica. Sin embargo, este marcador carece de especificidad diagnóstica, ya que puede estar elevado en múltiples condiciones no relacionadas, y solo es útil como herramienta complementaria, especialmente durante el seguimiento.
El test de supresión con clonidina constituye otra herramienta útil para distinguir entre elevaciones fisiológicas y patológicas de normetanefrina. Se administra clonidina oralmente y se mide la concentración de metanefrinas tres horas después. Una caída significativa de los niveles hacia el rango normal, o una disminución mayor al cuarenta por ciento desde el valor basal, sugiere una causa no tumoral.
Desde una perspectiva bioquímica general, pueden observarse alteraciones secundarias, como hiperglucemia leve en cerca del treinta y cinco por ciento de los pacientes, proteinuria en un diez a veinte por ciento, y leucocitosis frecuente, probablemente reflejo del estado hipermetabólico e inflamatorio inducido por la hipersecreción catecolaminérgica.
Imagen
La evaluación por imágenes desempeña un papel fundamental en el diagnóstico y la localización anatómica de los feocromocitomas y paragangliomas, tanto en su fase inicial como en el seguimiento posterior. La elección y secuencia de las técnicas de imagen responden a criterios clínicos, bioquímicos y genéticos, ya que ningún método es universalmente superior en todos los contextos. La estrategia diagnóstica se fundamenta en una aproximación escalonada, iniciando con estudios estructurales como la tomografía computarizada y la resonancia magnética, y complementándose con técnicas funcionales de imagen nuclear cuando estas no son concluyentes o se sospecha diseminación metastásica o localización extraadrenal.
Cuando se sospecha un feocromocitoma adrenal tras una evaluación clínica y bioquímica positiva, la primera línea de estudio suele ser la tomografía computarizada de abdomen sin contraste, con cortes finos centrados específicamente en las glándulas suprarrenales. Este enfoque permite identificar lesiones sólidas, su tamaño, densidad y características morfológicas. Sin embargo, está estrictamente contraindicado el uso de glucagón como agente provocador durante estos estudios, ya que puede desencadenar una crisis hipertensiva fulminante en pacientes con feocromocitoma, debido a la estimulación súbita de la liberación de catecolaminas por parte del tumor.
Por su parte, la resonancia magnética presenta varias ventajas comparativas. No requiere el uso de contraste intravenoso, lo que reduce el riesgo de reacciones adversas y evita la exposición a agentes yodados que podrían interferir con otros estudios funcionales. Además, al no emitir radiación ionizante, es el método de elección durante el embarazo y en situaciones que requieren vigilancia seriada, como el seguimiento de pacientes con predisposición genética. Tanto la tomografía computarizada como la resonancia magnética presentan una sensibilidad cercana al 90 por ciento para detectar feocromocitomas adrenales, y alcanzan hasta el 95 por ciento en tumores mayores de medio centímetro. Sin embargo, su sensibilidad disminuye de forma significativa en el contexto de tumores recurrentes, lesiones metastásicas y paragangliomas extraadrenales, especialmente aquellos de menor tamaño o localizados en sitios atípicos.
Ante la ausencia de una masa suprarrenal visible en los estudios iniciales, se extiende el campo de exploración por imágenes hacia el abdomen completo, la pelvis y el tórax, debido a que los paragangliomas pueden encontrarse en múltiples localizaciones extraadrenales, incluyendo el mediastino, la base del cráneo, el retroperitoneo y la vejiga, entre otros.
La imagenología nuclear representa una herramienta indispensable para la detección funcional de estos tumores, especialmente cuando la localización anatómica no es clara o cuando se sospecha enfermedad metastásica. La tomografía por emisión de positrones utilizando análogos de somatostatina marcados con galio-68, como el 68Ga-DOTATOC-PET, es actualmente la modalidad más sensible para la detección de feocromocitomas, paragangliomas y sus metástasis, alcanzando una sensibilidad cercana al 90 por ciento. No obstante, esta técnica no es completamente específica, ya que puede captar otras neoplasias neuroendocrinas o tejidos con alta expresión de receptores de somatostatina.
La calidad superior de imagen de la PET, en comparación con la gammagrafía convencional, permite una mejor delimitación del volumen tumoral, sobre todo cuando se combina con técnicas de imagen estructural como la tomografía computarizada o la resonancia magnética, integrando así información morfológica y funcional para una localización precisa. Otra modalidad de PET, la 18FDG-PET, tiene menor sensibilidad global (alrededor del 54 por ciento para metástasis), pero resulta particularmente útil en pacientes con mutaciones germinales en el gen SDHB, que se asocian con tumores agresivos y una mayor carga metastásica. Sin embargo, al igual que otras técnicas funcionales, la 18FDG-PET no es específica para feocromocitomas ni paragangliomas, ya que la captación de glucosa marcada también ocurre en procesos inflamatorios y otras neoplasias.
La gammagrafía con 123I-metayodobencilguanidina (123I-MIBG) representa una modalidad clásica de imagen funcional en estos tumores, particularmente útil para lateralizar masas adrenales sospechosas. Su sensibilidad supera el 90 por ciento para feocromocitomas adrenales, pero cae a un 67 por ciento para paragangliomas extraadrenales y metástasis. Su rendimiento diagnóstico es especialmente limitado en tumores asociados a síndromes genéticos como las neoplasias endocrinas múltiples tipo 2 o 3, y en aquellos de comportamiento agresivo, que a menudo pierden la capacidad de captar MIBG. Previo a su realización, se administra yoduro de potasio para bloquear la captación tiroidea del isótopo libre y evitar toxicidad tiroidea. Además, ciertos medicamentos pueden interferir negativamente con la captación del radiotrazador, generando resultados falsamente negativos. La ausencia de captación fisiológica en las glándulas salivales puede ser un indicador de interferencia farmacológica, por lo que es crucial revisar y suspender, cuando sea posible, estos fármacos antes de la realización del estudio.
Diagnóstico diferencial
El diagnóstico diferencial del feocromocitoma es clínicamente desafiante debido a la amplia superposición sintomática que presenta con múltiples entidades médicas que afectan los sistemas cardiovascular, endocrino, neurológico y renal. La variedad y la intensidad de los síntomas provocados por un feocromocitoma, como hipertensión paroxística, palpitaciones, diaforesis, cefalea y ansiedad, son comunes a otras enfermedades tanto benignas como graves, lo que puede llevar a diagnósticos erróneos y a retrasos potencialmente peligrosos en el tratamiento.
Una de las condiciones más importantes a considerar en el diagnóstico diferencial es la tirotoxicosis, que puede manifestarse con taquicardia, hipertensión sistólica, sudoración y pérdida de peso, mimetizando las crisis catecolaminérgicas del feocromocitoma. Sin embargo, en la tirotoxicosis, los niveles de metanefrinas plasmáticas suelen ser normales, y la presencia de niveles elevados de hormonas tiroideas libres ayuda a diferenciar ambas entidades.
La hipertensión esencial lábil también puede generar confusión diagnóstica, especialmente en pacientes jóvenes o ansiosos, en quienes las cifras de presión arterial fluctúan en función de factores emocionales. A diferencia del feocromocitoma, esta forma de hipertensión no suele acompañarse de descargas súbitas de catecolaminas, y los marcadores bioquímicos son normales.
Asimismo, ciertas condiciones cardiovasculares, como la miocarditis aguda, pueden inducir arritmias, dolor torácico y disfunción autonómica, lo que puede simular los efectos miocárdicos del exceso catecolaminérgico. A nivel renal, enfermedades como la glomerulonefritis o lesiones vasculares renales pueden inducir hipertensión secundaria severa, con proteinuria y hematuria, requiriendo una cuidadosa evaluación de la función renal y del sedimento urinario para excluir estas patologías.
Durante el embarazo, la eclampsia y la preeclampsia pueden cursar con hipertensión severa, proteinuria, cefalea, convulsiones y disfunción multiorgánica, reflejando muchas de las características clínicas de un feocromocitoma. Sin embargo, la ausencia de metanefrinas elevadas y la resolución espontánea tras el parto ayudan a establecer el diagnóstico diferencial.
Las enfermedades metabólicas y neurológicas también forman parte del espectro diferencial. La porfiria intermitente aguda, un trastorno del metabolismo del hemo, puede provocar episodios de dolor abdominal, vómitos, taquicardia, hipertensión y alteraciones neuropsiquiátricas. Los ataques de pánico o crisis de ansiedad pueden imitar las crisis adrenérgicas, con sensación de muerte inminente, sudoración, palpitaciones y disnea; sin embargo, la naturaleza psicógena de los episodios, su asociación con factores desencadenantes emocionales y la normalidad de los estudios hormonales permiten diferenciarlos.
El consumo de sustancias simpaticomiméticas como la cocaína o las anfetaminas también puede producir un cuadro clínico indistinguible de una crisis catecolaminérgica, ya que estas drogas inducen liberación masiva de noradrenalina y dopamina endógena. La abstinencia de clonidina, un agonista adrenérgico de acción central, también puede provocar un efecto rebote con hipertensión severa. Otro escenario relevante es el de pacientes tratados con inhibidores no selectivos de la monoaminooxidasa (MAO); en estos casos, la ingestión de alimentos ricos en tiramina puede desencadenar una crisis hipertensiva peligrosa, resultado de una acumulación de aminas vasoactivas que no pueden ser degradadas eficientemente.
En el ámbito de los síndromes vasomotores, la inestabilidad vascular secundaria a hipogonadismo, comúnmente manifestada como sofocos, puede generar síntomas vegetativos como palpitaciones y sudoración, que simulan una descarga adrenérgica. La eritromelalgia, una enfermedad rara caracterizada por dolor, enrojecimiento y calor en las extremidades, también puede asociarse a crisis hipertensivas episódicas.
Desde el punto de vista diagnóstico, incluso los estudios bioquímicos y de imagen pueden ser fuente de confusión. Las metanefrinas plasmáticas fraccionadas pueden estar elevadas en ausencia de un tumor catecolaminérgico funcional en situaciones como la apnea del sueño o enfermedades agudas severas, debido a una activación del sistema simpático que imita bioquímicamente al feocromocitoma. Por ello, los resultados deben interpretarse en el contexto clínico global y, de ser necesario, repetirse bajo condiciones estandarizadas para reducir los falsos positivos.
En los estudios de imagen, las masas suprarrenales deben diferenciarse cuidadosamente. En la tomografía computarizada, los feocromocitomas deben distinguirse de adenomas suprarrenales no funcionales y otras lesiones como quistes, mielolipomas o carcinomas. En la gammagrafía con 123I-metayodobencilguanidina, la captación del radiotrazador en las glándulas suprarrenales puede representar una captación fisiológica o, en ocasiones, puede observarse incluso en adenomas benignos, lo que limita la especificidad del estudio. Por ello, se requiere experiencia clínica y una integración cuidadosa de los hallazgos bioquímicos, clínicos y radiológicos para establecer el diagnóstico definitivo.
Complicaciones
El feocromocitoma, debido a su capacidad para secretar catecolaminas de forma desregulada e intermitente, puede desencadenar una amplia gama de complicaciones hemodinámicas y sistémicas, muchas de las cuales pueden poner en peligro la vida. La secreción excesiva y episódica de adrenalina, noradrenalina y, en algunos casos, dopamina, produce efectos cardiovasculares extremos que sobrecargan al sistema circulatorio y afectan múltiples órganos. En este contexto, las crisis hipertensivas no son simplemente un síntoma más del feocromocitoma, sino una manifestación central de su fisiopatología, que puede evolucionar hacia consecuencias devastadoras.
Entre las complicaciones más frecuentes se encuentran aquellas típicamente asociadas con hipertensión severa no controlada. Estas incluyen insuficiencia cardíaca, disección aórtica, retinopatía hipertensiva, encefalopatía hipertensiva, daño renal agudo y eventos cerebrovasculares. Sin embargo, los feocromocitomas presentan un patrón más impredecible y peligroso, ya que las crisis adrenérgicas paroxísticas provocan elevaciones abruptas y masivas de la presión arterial, seguidas a veces de descensos bruscos, lo que genera inestabilidad hemodinámica significativa.
Una complicación grave y característica de estos tumores es la miocardiopatía inducida por catecolaminas. Esta condición se desarrolla debido al efecto tóxico directo de altas concentraciones de catecolaminas sobre el miocardio, que producen necrosis, fibrosis y disfunción ventricular. Esta miocardiopatía puede adoptar formas reversibles, como el síndrome de Takotsubo, o progresar hacia insuficiencia cardíaca severa con bajo gasto, colapso circulatorio y, en algunos casos, muerte súbita por arritmias ventriculares malignas. Estos eventos pueden desencadenarse espontáneamente o ser precipitados por estímulos mecánicos o farmacológicos, como cirugía, trauma, anestesia, biopsias o parto.
Otra complicación aguda es el síndrome de distrés respiratorio agudo (ARDS), resultado de la injuria endotelial y la respuesta inflamatoria sistémica que puede acompañar una crisis catecolaminérgica. En casos extremos, se produce una crisis multisistémica, caracterizada por insuficiencia respiratoria, cardiogénica y renal, hipotensión refractaria y alteraciones metabólicas severas. En estos pacientes, la presentación inicial del feocromocitoma puede ser el shock, o incluso el colapso cardiovascular súbito, sin una hipertensión previa evidente. Esta variabilidad en la presentación clínica contribuye a que muchos diagnósticos se realicen tardíamente o durante la emergencia médica.
No es infrecuente que las crisis hipertensivas provoquen accidentes cerebrovasculares, ya sea por ruptura vascular con hemorragia intracraneal o por vasoespasmo con isquemia cerebral. La pérdida visual súbita, secundaria a neuropatía óptica isquémica o retinopatía hipertensiva aguda, también puede ser una manifestación inicial o concomitante.
La extirpación quirúrgica del tumor, aunque curativa en la mayoría de los casos, puede traer complicaciones hemodinámicas inesperadas. Tras la resección del feocromocitoma, el paciente puede experimentar una caída abrupta de las catecolaminas circulantes, lo que provoca vasodilatación súbita y una hipotensión severa y prolongada. Esta situación puede ser refractaria incluso al uso de agentes vasopresores como adrenalina y noradrenalina, debido a la desensibilización previa de los receptores adrenérgicos por exposición crónica. Esta hipotensión postoperatoria puede precipitar eventos isquémicos como infarto agudo de miocardio o lesión renal aguda por hipoperfusión.
Otra fuente de complicaciones potencialmente letales es la necrosis espontánea o la hemorragia intratumoral del feocromocitoma. La ruptura vascular dentro del tumor puede liberar grandes cantidades de catecolaminas en circulación o provocar un colapso hemodinámico por sangrado masivo, presentándose como dolor abdominal agudo, hipotensión y shock.
En cuanto al comportamiento tumoral, aunque los feocromocitomas y paragangliomas son mayoritariamente benignos, pueden metastatizar en una proporción no despreciable, especialmente en presencia de mutaciones genéticas como las del gen SDHB. Las metástasis pueden afectar hígado, pulmones, hueso y ganglios linfáticos, y suelen mantener la capacidad secretora, perpetuando el riesgo de crisis catecolaminérgicas. Además, durante la manipulación quirúrgica o en algunos casos espontáneamente, las células tumorales pueden diseminarse dentro del peritoneo, provocando la siembra de múltiples focos tumorales intraabdominales. Esta entidad, conocida como feocromocitomatosis, representa una forma agresiva y recurrente de la enfermedad, de difícil control clínico y con implicancias terapéuticas complejas.
Tratamiento
Médico
El manejo preoperatorio del paciente con feocromocitoma o paraganglioma es un componente crítico para reducir la morbimortalidad asociada a la resección quirúrgica de estos tumores. La liberación masiva e impredecible de catecolaminas por parte de estas neoplasias representa un riesgo significativo de crisis hipertensivas, arritmias ventriculares, infarto agudo de miocardio, edema pulmonar, y muerte súbita durante la inducción anestésica o la manipulación del tumor. Por ello, es imperativo establecer un control farmacológico eficaz previo a la cirugía, cuyo objetivo principal es estabilizar la presión arterial, normalizar la frecuencia cardíaca, y reducir la reactividad vascular adrenérgica.
Todos los pacientes diagnosticados con feocromocitoma o paraganglioma simpático deben someterse a un período de preparación médica, salvo aquellos que se mantengan normotensos de forma sostenida. La medición diaria de la presión arterial es recomendada, y en pacientes que experimentan crisis paroxísticas, se les instruye sobre cómo registrar sus cifras tensionales inmediatamente durante dichos episodios para evaluar con precisión la magnitud de las variaciones hemodinámicas. Esta vigilancia permite ajustar la terapéutica de forma individualizada y oportuna.
El tratamiento farmacológico debe iniciarse, en la mayoría de los casos, con bloqueadores alfa-adrenérgicos, que contrarrestan los efectos vasoconstrictores periféricos de la noradrenalina. La fenoxibenzamina es el agente clásico en esta categoría; se trata de un bloqueador alfa no selectivo y de acción prolongada, con una semivida de aproximadamente 24 horas. Se administra por vía oral a dosis iniciales de 10 miligramos cada 12 horas, y se incrementa gradualmente —en general 10 miligramos por día cada tres días— hasta alcanzar un control adecuado de la hipertensión. Las dosis de mantenimiento oscilan entre 10 y 120 miligramos diarios, dependiendo de la respuesta individual.
Como alternativa, los bloqueadores alfa-1 selectivos como la doxazosina se han popularizado por su menor incidencia de efectos adversos como la fatiga, la congestión nasal y la hipotensión ortostática. La doxazosina tiene una semivida similar a la de la fenoxibenzamina (alrededor de 22 horas) y se administra en dosis de entre 2 y 32 miligramos diarios. El objetivo de una adecuada preparación alfa-bloqueante es lograr una presión arterial en decúbito inferior a 140/90 milímetros de mercurio, manteniendo al mismo tiempo una presión arterial en bipedestación superior a 80/45 milímetros de mercurio, evitando así el riesgo de hipotensión ortostática sintomática.
Los bloqueadores de los canales de calcio, como la nifedipina de liberación prolongada o la nicardipina, son agentes muy eficaces que pueden ser utilizados solos o en combinación con bloqueadores alfa. La nifedipina se inicia a una dosis de 30 miligramos diarios y puede aumentarse gradualmente hasta un máximo de 60 miligramos dos veces al día. Estos agentes son particularmente útiles para el manejo a largo plazo debido a su perfil de efectos adversos más favorable en comparación con la fenoxibenzamina, aunque deben evitarse en pacientes con insuficiencia cardíaca severa, ya que pueden deteriorar aún más la función ventricular.
En situaciones de crisis hipertensiva aguda, definida como una presión arterial sistólica mayor a 170 milímetros de mercurio, se puede utilizar nifedipina de acción inmediata. Una cápsula de 10 miligramos puede ser masticada y deglutida, lo que resulta en una disminución efectiva de la presión arterial incluso en el entorno ambulatorio, siempre que se realice bajo monitoreo cuidadoso. Esta estrategia ha demostrado ser razonablemente segura y eficaz en pacientes con feocromocitoma o paraganglioma.
Una vez que se ha logrado un bloqueo alfa adecuado, se puede introducir un betabloqueador cardioselectivo como el metoprolol de liberación prolongada para controlar las taquiarritmias. Es fundamental que este paso se realice solo después del establecimiento de un adecuado bloqueo alfa, ya que el uso de betabloqueadores como monoterapia en estos pacientes puede precipitar una crisis hipertensiva severa por el fenómeno de “estimulación alfa no contrarrestada”, conocido como efecto alfa desinhibido. Este fenómeno ocurre porque al bloquear los receptores beta, la estimulación adrenérgica residual actúa exclusivamente sobre los receptores alfa, intensificando la vasoconstricción periférica.
El labetalol, que posee actividad bloqueante tanto alfa como beta, puede ser útil en ciertas situaciones, pero debe utilizarse con precaución. Aunque teóricamente ofrece un control dual, su efecto alfa no es tan potente como el de la fenoxibenzamina, y su uso como primer agente antihipertensivo también puede inducir hipertensión paradójica en algunos pacientes.
En el caso de pacientes normotensos, especialmente aquellos con feocromocitomas no secretantes o con secreción mínima, la premedicación con bloqueadores alfa puede ser innecesaria. En estos casos, la administración de tales agentes podría inducir hipotensión preoperatoria y aumentar la necesidad de vasopresores y soluciones coloidales durante el período posquirúrgico inmediato. Por ello, el manejo debe individualizarse, tomando en cuenta no solo los valores de presión arterial, sino también los síntomas clínicos, la carga catecolaminérgica, y los hallazgos bioquímicos y radiológicos.
Quirúrgico
La resección quirúrgica de los feocromocitomas y los paragangliomas abdominales constituye el tratamiento de elección, tanto en casos esporádicos como hereditarios, debido a su potencial curativo cuando se logra la extirpación completa del tumor secretor de catecolaminas. Esta intervención permite eliminar la fuente patológica de secreción adrenérgica descontrolada, restaurar la estabilidad hemodinámica y prevenir complicaciones cardiovasculares, metabólicas y neurológicas potencialmente letales. Sin embargo, el procedimiento conlleva importantes riesgos, y por ello requiere una preparación meticulosa y un abordaje multidisciplinario coordinado.
El éxito de la cirugía depende críticamente de la participación conjunta de un equipo especializado que incluya endocrinólogos, anestesiólogos y cirujanos con experiencia en el manejo de estas neoplasias altamente funcionales. La participación activa del endocrinólogo permite optimizar la preparación farmacológica preoperatoria y monitorear las manifestaciones bioquímicas de la enfermedad. El anestesiólogo tiene un rol esencial en el manejo intraoperatorio de las oscilaciones hemodinámicas intensas provocadas por la manipulación del tumor, mientras que el cirujano debe estar preparado para adaptar la técnica quirúrgica a las características anatómicas y biológicas del tumor.
Siempre que sea posible, se prefiere la resección laparoscópica por su menor agresividad, tiempos de recuperación más cortos y menor sangrado intraoperatorio. No obstante, en el caso de tumores grandes, invasivos o con sospecha de malignidad, se recomienda una laparotomía abierta, que permite un abordaje más amplio, mayor control vascular y evaluación directa de estructuras adyacentes comprometidas. En pacientes con feocromocitomas bilaterales o familiares, se puede considerar la resección parcial suprarrenal con preservación del córtex adrenal, con el fin de evitar insuficiencia suprarrenal crónica y dependencia de esteroides. No obstante, este enfoque conlleva una tasa de recurrencia cercana al 10% a los 10 años, lo que justifica un seguimiento prolongado y riguroso.
Es fundamental que antes de la intervención quirúrgica se logre un control hemodinámico óptimo, que incluya estabilización de la presión arterial durante al menos cuatro a siete días consecutivos, así como una evaluación y mejoría del estado cardíaco. En pacientes con miocarditis inducida por catecolaminas, pueden observarse cambios electrocardiográficos que demoran semanas o incluso meses en revertirse, por lo que en tales casos puede ser prudente posponer la cirugía hasta alcanzar una recuperación funcional aceptable del miocardio.
Durante el procedimiento quirúrgico, es esencial mantener una monitorización hemodinámica intensiva. El tumor puede liberar grandes cantidades de catecolaminas al ser manipulado, lo que provoca elevaciones súbitas de la presión arterial, arritmias malignas o incluso colapso cardiovascular. La anestesia debe ser cuidadosamente adaptada, utilizando agentes que minimicen la estimulación simpática y que permitan respuestas rápidas a los cambios circulatorios.
Para reducir el riesgo de hipotensión postoperatoria severa —frecuente tras la resección del tumor por la pérdida súbita del estímulo catecolaminérgico crónico y la desensibilización de los receptores alfa-1 vasculares— se recomienda realizar autotransfusión de una a dos unidades de sangre propias aproximadamente 12 horas antes de la cirugía, así como una reposición generosa de volumen durante el procedimiento. Esta estrategia mejora la precarga y atenúa la caída brusca de la presión arterial tras la extirpación tumoral.
En caso de presentarse un estado de choque tras la resección, se indica la administración inmediata de solución salina o coloides por vía intravenosa, y, si es necesario, el uso de altas dosis de norepinefrina intravenosa para restaurar el tono vascular. La recuperación hemodinámica puede ser lenta, ya que el sistema vascular ha estado adaptado a un estado de vasoconstricción mantenida y requiere tiempo para readaptarse al nuevo entorno normoadrenérgico.
En el período posoperatorio, es común que los pacientes experimenten hipoglucemia reactiva, especialmente en aquellos que presentaban hiperglucemia previa relacionada con el exceso de catecolaminas. Para prevenir este fenómeno, se infunde dextrosa al 5% de manera continua en el posoperatorio inmediato, vigilando cuidadosamente los niveles séricos de glucosa.
Pronóstico
El pronóstico de los pacientes con feocromocitomas que son reseccionados antes de que causen daño cardiovascular es generalmente favorable. La eliminación quirúrgica completa del tumor, que es la estrategia terapéutica de elección, a menudo permite la normalización de la presión arterial, que suele mejorar o incluso resolverse en la mayoría de los casos. Sin embargo, a pesar de una cirugía exitosa, alrededor del 25% de los pacientes pueden experimentar persistencia o recurrencia de la hipertensión. Esto se debe a diversas razones, que incluyen la presencia de un segundo feocromocitoma o la existencia de metástasis no detectadas en el momento de la resección inicial. En tales casos, se requiere una reevaluación bioquímica detallada para confirmar si existe un tumor residual o metastásico.
La mortalidad quirúrgica en pacientes con feocromocitomas que se someten a resección quirúrgica es relativamente baja, con una tasa inferior al 3%, especialmente cuando se emplean técnicas quirúrgicas laparoscópicas, monitoreo intraoperatorio y un control preoperatorio adecuado de la presión arterial con bloqueadores alfa o bloqueadores de los canales de calcio. Estos avances en la cirugía mínimamente invasiva y en el manejo anestésico han mejorado significativamente los resultados, reduciendo las complicaciones asociadas al manejo de los efectos hemodinámicos durante la cirugía.
Es importante resaltar que, aunque no se evidencien metástasis en el momento de la cirugía, los pacientes requieren una vigilancia a lo largo de toda su vida, ya que las metástasis pueden desarrollarse años o incluso décadas después de la resección del tumor primario. La detección temprana de metástasis es esencial, y la monitorización debe incluir evaluaciones periódicas de los niveles de catecolaminas y pruebas de imagen, como tomografías o resonancias magnéticas, para identificar posibles recurrencias o diseminaciones a otras partes del cuerpo.
La tasa de recurrencia después de la resección de feocromocitomas es relativamente baja en los casos esporádicos, con una incidencia de alrededor del 15%, tanto en los feocromocitomas esporádicos como en los paragangliomas, incluidos aquellos con mutaciones germinales que activan quinasas. Sin embargo, en pacientes con mutaciones germinales de SDHX, que están asociadas con la activación de vías pseudohipóxicas, la tasa de recurrencia se eleva considerablemente, alcanzando un 47%. Esto subraya la importancia de un enfoque genético en el tratamiento y seguimiento de estos pacientes, dado que la presencia de mutaciones específicas puede influir significativamente en el pronóstico a largo plazo.
Los pacientes con paragangliomas y feocromocitomas metastásicos tienen un pronóstico extremadamente variable. Algunas metástasis pueden permanecer indolentes durante décadas después del diagnóstico del tumor primario, lo que complica la predicción del comportamiento tumoral. En general, la supervivencia general es mejor para aquellos pacientes con tumores no funcionales, aquellos que presentan una alta captación de 123-Iodo-metaiodobenzilguanidina (MIBG) en las imágenes, o con un índice de proliferación celular Ki67 inferior al 10%. Los tumores con características favorables, como una baja tasa de proliferación celular y una captación aumentada por MIBG, tienden a tener un pronóstico más favorable y, por ende, a mostrar una menor propensión a desarrollar metástasis rápidamente.
Además, los paragangliomas de cabeza y cuello son conocidos por su comportamiento particularmente lento en cuanto al crecimiento de las metástasis. A pesar de su naturaleza metastásica, estos tumores tienen una tendencia a progresar de manera más pausada que otros tipos de paragangliomas, lo que contribuye a un mejor pronóstico a largo plazo para los pacientes que padecen esta forma de la enfermedad.

Fuente y lecturas recomendadas:
Cascón A et al. Genetic bases of pheochromocytoma and paraganglioma. J Mol Endocrinol 2023;70:e220167. [PMID: 36520714]
Eisenhofer G et al. Biochemical assessment of pheochromocytoma and paraganglioma. Endocr Rev. 2023;44:862. [PMID: 36996131]
Hashmi HZ et al. What is the rationale for the laboratory workup for suspected pheochromocytomas and paragangliomas? Cleve Clin J Med. 2023;90:150. [PMID: 36958610]
Li M et al. Recurrent disease in patients with sporadic pheochromocytoma and paraganglioma. J Clin Endocrinol Metab. 2023;108:397. [PMID: 36190922]
Zhou Y et al. Efficacy and safety of tyrosine kinase inhibitors in patients with metastatic pheochromocytomas/paragangliomas. J Clin Endocrinol Metab. 2023;108:755. [PMID: 36383456]